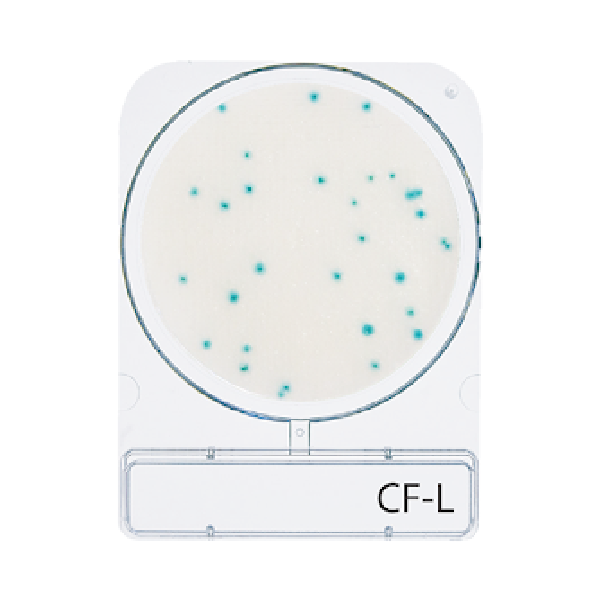

- ANASAYFA
- KURUMSAL
- HAKKIMIZDA
- EĞİTİM ve DANIŞMANLIK
- HABERLER
- Corona Hijyen Ölçümü
- Corona Dezenfeksiyon
- Corona Dezenfeksiyon Ölçümü
- Dezenfektan Kontrol Cihazı
- Bakteri Ölçüm Cihazı
- Virüs Ölçüm Cihazı
- Hijyen Kontrol Cihazı
- ATP Hijyen Monitörü
- Virüs ve Bakteri Kontrolü
- Hazır Besiyeri
- ATP Ölçüm Cihazı
- ADP Ölçüm Cihazı
- AMP Ölçüm Cihazı
- Hastaneler İçin Virüs Ölçüm Cihazı
- Hastaneler İçin Bakteri Ölçüm Cihazı
- Tıbbi Cihazlar Virüs Ölçümü
- Tıbbi Cihazlar Bakteri Ölçümü
- TEMSİLCİLİKLER
- ÜRÜNLER
- VİDEOLAR
- BLOG
- İLETİŞİM

1. ADIM
Kapağı çıkarın.

2. ADIM
Compact Dry plakasının ortasına 1 mL numune koyun.

3. ADIM
Numune, kurutulmuş ortam tabakası boyunca pasif ve eşit bir şekilde yayılır ve kuru ortamı saniyeler içinde bir jele dönüştürür.

4. ADIM
Kapağı yerine takın ve plakayı etiketleyin.

5. ADIM
Plakayı ters çevirin (kapak kapalı) ve uygun süre ve sıcaklıkta inkübe edin.

6. ADIM
İnkübasyonun ardından renkli mikrobiyal kolonilerin sayısını sayın.